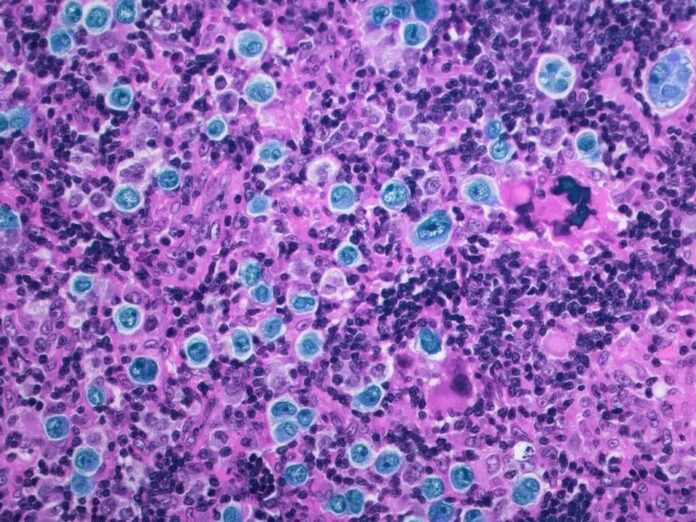

Avance Revolucionario en el Tratamiento del Linfoma de Hodgkin
Un equipo de científicos en Israel ha logrado un hito sin precedentes en la lucha contra el linfoma de Hodgkin, una forma de cáncer que afecta a los linfocitos y que, si se detecta a tiempo, puede ser curado. Ahora, un tratamiento innovador promete remisiones completas en pacientes en etapas avanzadas de la enfermedad.
Los linfomas, que son cánceres del sistema linfático, afectan aproximadamente a una de cada 5,000 personas. La clave para un tratamiento eficaz radica en la detección temprana. Sin embargo, el nuevo estudio revela avances que podrían cambiar el panorama para quienes enfrentan un diagnóstico complicado, especialmente del linfoma de Hodgkin.
¿Qué es el Linfoma de Hodgkin?
El linfoma de Hodgkin es menos común que su contraparte, el linfoma no Hodgkin, afectando mayormente a adultos jóvenes. Este tipo de cáncer se manifiesta principalmente en la parte superior del cuerpo, incluyendo axilas, cuello y pecho.
Nuevas Terapias Dirigidas: Un Cambio de Paradigma
Tradicionalmente, la quimioterapia ha sido el tratamiento estándar para el linfoma de Hodgkin avanzado. Sin embargo, gracias a la investigación en nuevas drogas, se han introducido terapias dirigidas que ofrecen mayores beneficios y menos efectos secundarios.
El Innovador Protocolo BrECADD
Investigadores del Ichilov Medical Center en Tel Aviv han estudiado el protocolo terapéutico conocido como BrECADD, que utiliza una mezcla de seis fármacos. Este enfoque combina quimioterapia avanzada con anticuerpos monoclonales, permitiendo atacar directamente las células cancerosas sin dañar el tejido sano.
Resultados Impactantes en Pacientes
El análisis de este tratamiento se presentó en el congreso de la Sociedad Americana de Hematología, donde se destacó el uso de «evidencia del mundo real» obtenida de 79 pacientes tratados en 15 centros de salud en Israel. De estos, el 83% fueron diagnosticados en estado IV, la fase más crítica.
Los resultados fueron sorprendentes: una tasa de supervivencia a un año del 100% y un impresionante 95% de los pacientes alcanzaron la remisión total, superando notablemente los resultados de ensayos anteriores.
Una Revolución en el Tratamiento
Más revelador aún, muchos pacientes lograron una «respuesta metabólica completa» tras solo dos ciclos de tratamiento, en un corto plazo de nueve semanas. Solo un 4% necesitó radioterapias tradicionales, una reducción significativa en efectos tóxicos.
Tzofia Levy, hematóloga del Rambam Health Care Campus y coautora del estudio, calificó este avance como «una verdadera revolución», afirmando que los pacientes pueden lograr un control total de la enfermedad en un tiempo récord.
Colaboración y Validación en el Mundo Real
Roy Vitkon, otro de los especialistas involucrados, expresó la importancia de confirmar estos resultados prometedores en un entorno práctico. «Somos pioneros en publicar datos que demuestran este protocolo en la vida real», subrayó, destacando la efectiva colaboración entre múltiples centros médicos.